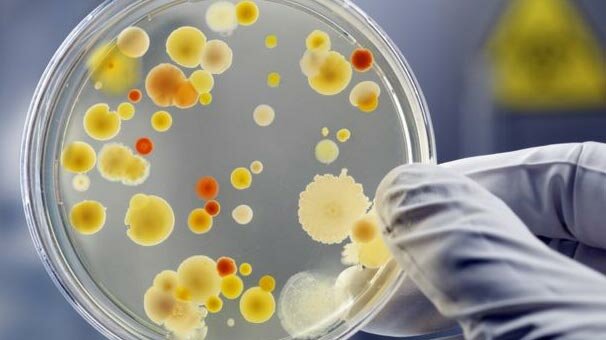
Bakterilerin havada binlerce kilometre gidebildiği tespit edildi

"Rusya" İLE İLGİLİ HABERLER

ABD Adalet Bakanı William Barr, Rusya soruşturmasını yürüten Özel Yetkili Savcı Robert Mueller'ın yaklaşık 400 sayfalık..

Rus mevkidaşı Lavrov ile Antalya’da bir araya gelen Dışişleri Bakanı Mevlüt Çavuşoğlu, Türkiye ile Rusya’nın S-400 için ..

Çin’in 65 tonluk tıbbi malzemeyi taşıyan uçağı Venezuela’ya ulaştı.
Devlet Başkanı Nicolas Maduro 65 tonluk tıbbiyar..

ABD Başkanı Donald Trump, Özel Yetkili Savcı Robert Mueller’ın yürüttüğü Rusya soruşturmasının tamamlanmasının ardından,..

Dışişleri Bakanı Mevlüt Çavuşoğlu ve Rusya Federasyonu Dışişleri Bakanı Sergey Lavrov arasındaki ikili görüşme Antalya'..

ABD Senatosu'na, Rusya’dan S-400 hava savunma sistemleri aldığı gerekçesiyle Türkiye'ye F-35 savaş uçaklarının transferl..
ABD'li bilim adamlarının yaptığı bir araştırma, bakterilerin hava yoluyla bir insana ya da hayvana bağlı kalmadan tek b..

ABD Başkanı Donald Trump, Özel Yetkili Savcı Robert Mueller'ın yürüttüğü Rusya soruşturması için, "Bu soruşturma hükümet..

Dışişleri Bakanı Mevlüt Çavuşoğlu, 29 Mart’ta Rusya Dışişleri Bakanı Sergey Lavrov ile Antalya’da bir araya gelecek...
ÇOK OKUNAN HABERLER
- BUGÜN
- BU HAFTA
- BU AY
143 Okunma
138 Okunma
106 Okunma
106 Okunma
105 Okunma
105 Okunma
104 Okunma
103 Okunma
143 Okunma
138 Okunma
106 Okunma
106 Okunma
105 Okunma
105 Okunma
104 Okunma
103 Okunma
SON YORUMLANANLAR
- HABERLER
- VİDEOLAR


 İzmir Buca Belediyesi'ne rüşvet ve irtikap operasyonu düzenlendi. 62 şüpheli hak..
İzmir Buca Belediyesi'ne rüşvet ve irtikap operasyonu düzenlendi. 62 şüpheli hak.. Türk savunma sanayisinin zırhlı kara aracı üreticilerinden Katmerciler, yenilene..
Türk savunma sanayisinin zırhlı kara aracı üreticilerinden Katmerciler, yenilene.. İngiltere'de yaşayan bir adam, başkaları adına konser, mağaza açılışı ve ürün la..
İngiltere'de yaşayan bir adam, başkaları adına konser, mağaza açılışı ve ürün la.. İstanbul’da milyonlarca sürücüyü ilgilendiren kritik trafik düzenlemesi devreye ..
İstanbul’da milyonlarca sürücüyü ilgilendiren kritik trafik düzenlemesi devreye .. İtalyan sanatçı Maurizio Cattelan'ın milyonlarca dolar değerindeki "Komedyen" ad..
İtalyan sanatçı Maurizio Cattelan'ın milyonlarca dolar değerindeki "Komedyen" ad.. Amerika Birleşik Devletleri, Birleşik Krallık ve Avustralya, gelişmiş su altı dr..
Amerika Birleşik Devletleri, Birleşik Krallık ve Avustralya, gelişmiş su altı dr.. Türkiye ekonomisi, yılın ilk çeyreğinde yüzde 2,5 büyüme gösterdi. Hazine ve Mal..
Türkiye ekonomisi, yılın ilk çeyreğinde yüzde 2,5 büyüme gösterdi. Hazine ve Mal.. İsrail ordusunun Orta Doğu'daki skandal eylemleri sürüyor. İsrail Başbakanı Neta..
İsrail ordusunun Orta Doğu'daki skandal eylemleri sürüyor. İsrail Başbakanı Neta.. MHP Genel Başkanı Devlet Bahçeli, seçimlerin ardından partisinin ilk grup toplan..
MHP Genel Başkanı Devlet Bahçeli, seçimlerin ardından partisinin ilk grup toplan.. Uluslararası marka değerlendirme kuruluşu Brand Finance'ın araştırmasına göre, T..
Uluslararası marka değerlendirme kuruluşu Brand Finance'ın araştırmasına göre, T.. MHP Genel Başkanı Devlet Bahçeli'nin partisinin grup toplantısında yaptığı "100 ..
MHP Genel Başkanı Devlet Bahçeli'nin partisinin grup toplantısında yaptığı "100 ..